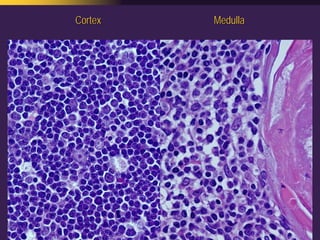
Mediastinal  Pathology  Compartmental  Approach
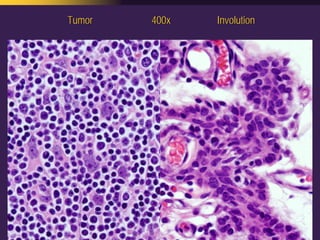
Mediastinal  Pathology  Compartmental  Approach
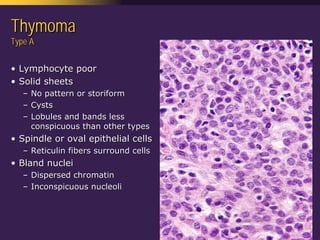
Mediastinal  Pathology  Compartmental  Approach
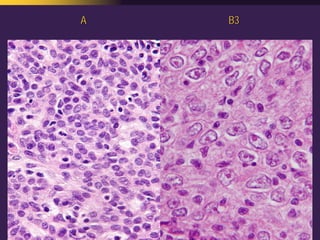
Mediastinal  Pathology  Compartmental  Approach

Embed presentation
Download as PDF, PPTX
























































































































This document discusses mediastinal pathology using a compartmental approach. It describes the anatomy of the mediastinum and divides it into anterior, middle, and posterior compartments. Each compartment contains different structures and has a characteristic distribution of lesions. For example, 50% of lesions occur in the anterior compartment, which contains the thymus. The thymus is the most common site of lesions in the anterior compartment. Thymomas are the most common epithelial tumors of the thymus and mediastinum.